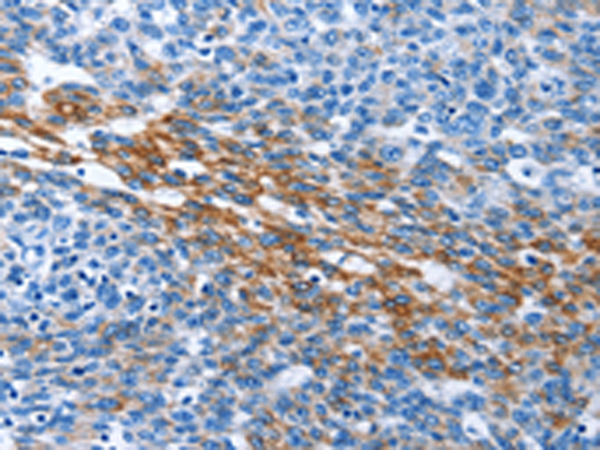
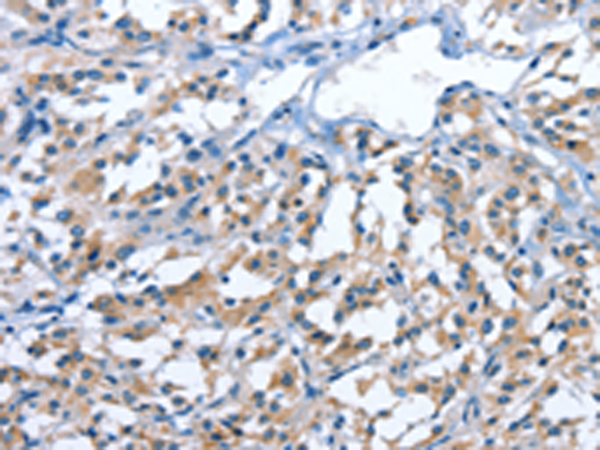
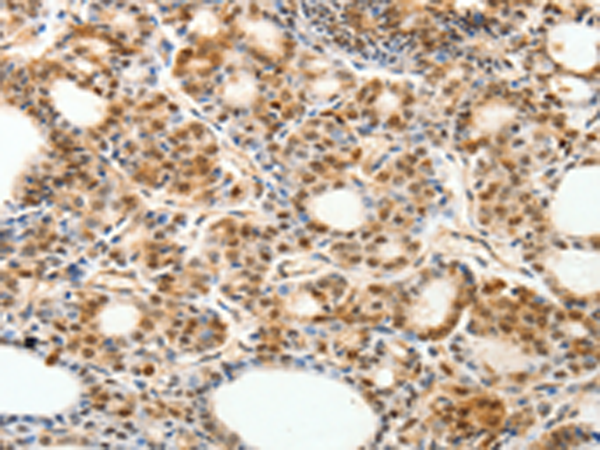
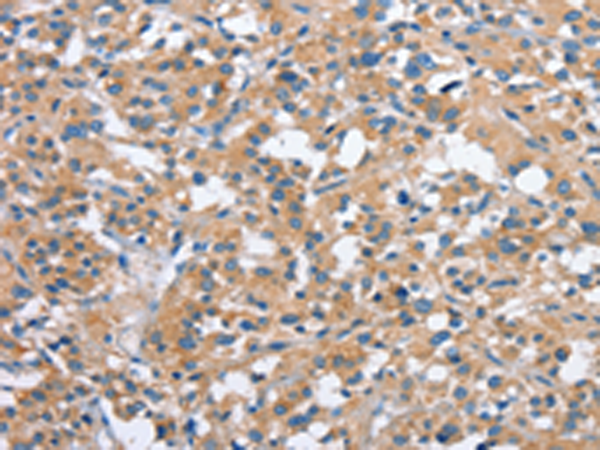
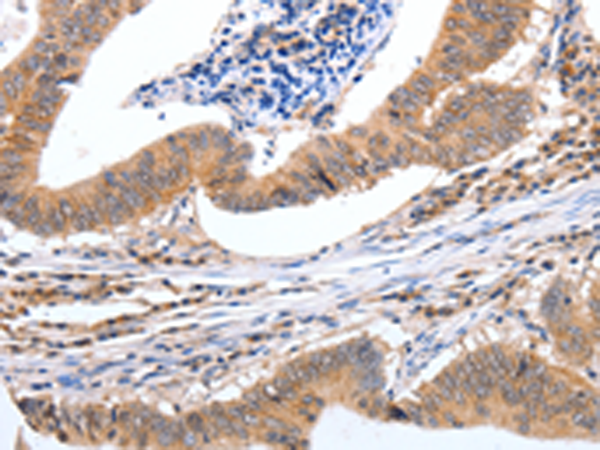

-
分类: 科研抗体货号: P07530别名: TFAR19应用: IHC反应种属: Human, Mouse
-
分类: 科研抗体货号: P07512别名: MEK3; MKK3; MAPKK3; PRKMK3; SAPKK2; SAPKK-2应用: WB,IHC反应种属: Human, Mouse
-
分类: 科研抗体货号: P07521别名: PAK5应用: IHC反应种属: Human, Mouse
-
分类: 科研抗体货号: P07511别名: RK; p38; CSBP; EXIP; Mxi2; CSBP1; CSBP2; CSPB1; PRKM14; PRKM15; SAPK2A; p38ALPHA应用: IHC反应种属: Human, Mouse, Rat
-
分类: 科研抗体货号: P07528别名: ALG-2, PEF1B应用: WB,IHC反应种属: Human, Mouse
-
分类: 科研抗体货号: P07520别名: PAK65; PAKgamma应用: WB,IHC反应种属: Human, Mouse, Rat
-
分类: 科研抗体货号: P07510别名: CARF应用: IHC反应种属: Human
-
分类: 科研抗体货号: P07526别名: CDHP; HJMD; PCAD应用: WB,IHC反应种属: Human
-
分类: 科研抗体货号: P07519别名: GDN; PI7; PN1; PNI; PI-7; PN-1; GDNPF应用: WB,IHC反应种属: Human, Mouse, Rat
-
分类: 科研抗体货号: P07538别名: PEPC, PGII应用: WB,IHC反应种属: Human

鄂公网安备42018502007531号
鄂公网安备42018502007531号

